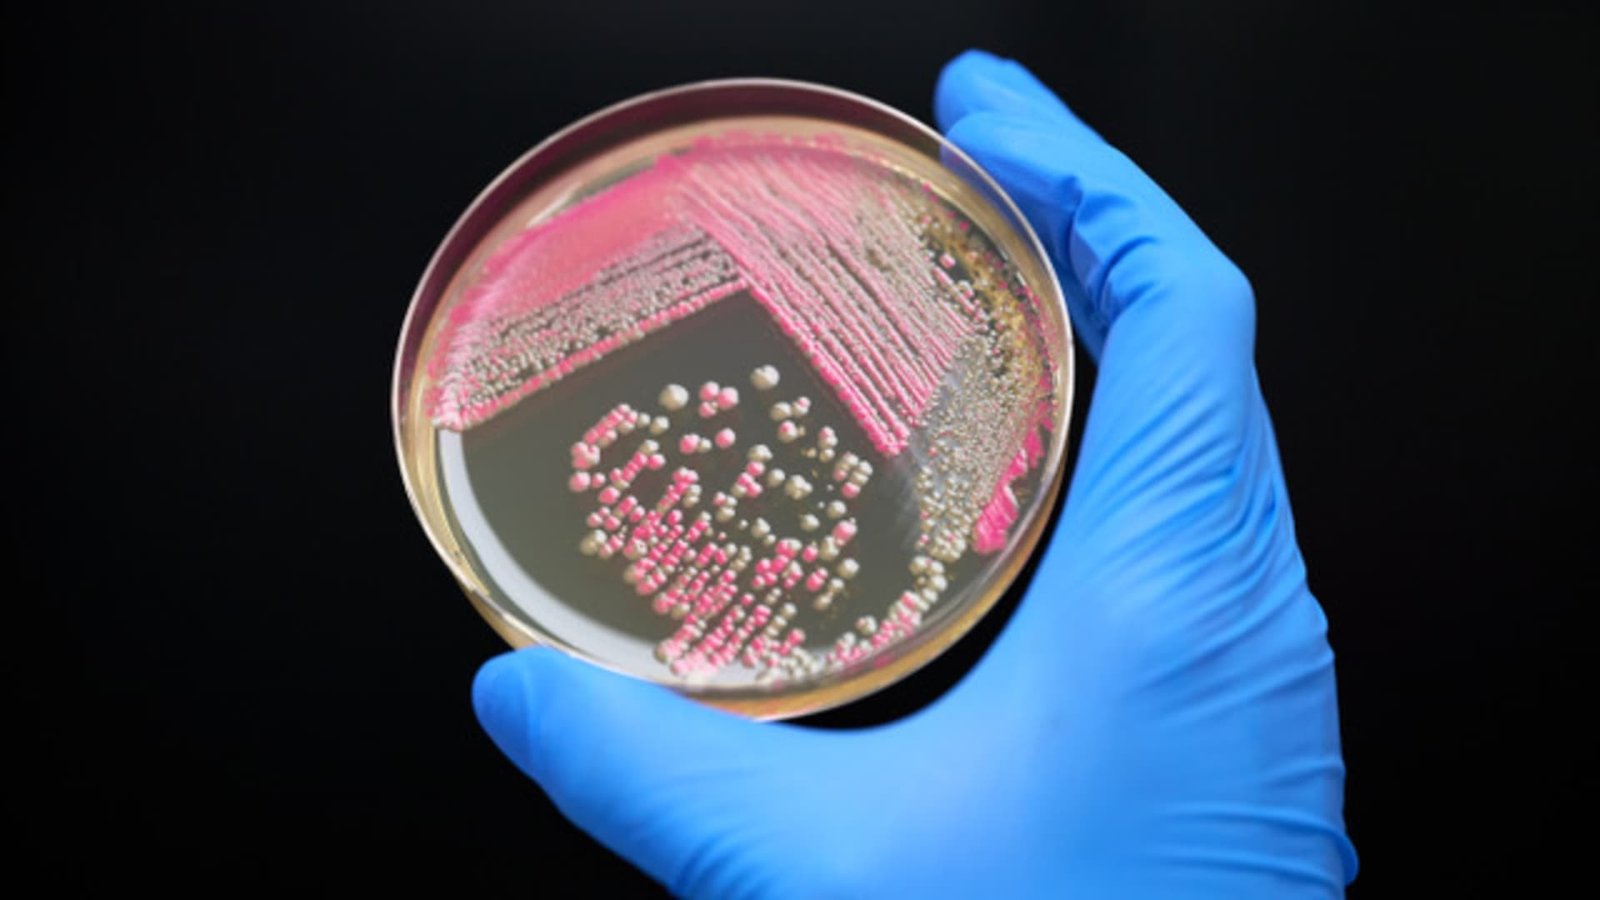

Trading cards of the game “Magic” are located in a shop where a “Magic” tournament is taking place.
Frank Rumpenhorst | picture alliance | Getty Images
As screentime soars and technology races ahead, a low-tech pastime is back in a big way: collecting trading cards.
The cardstock depicting everything from NFL standouts to Pokémon and even Taylor Swift is one of the hottest toy categories in stores this year. Big-box retailers are stocking up ahead of the holidays, anticipating that demand will extend beyond traditional toy buyers like children and collectors.
“We see trading cards being a hot gifting category for all ages that we will fuel with newness and with exclusive drops,” Rick Gomez, Target’s executive vice president and chief commercial officer, told CNBC. “We’re going to have new releases nearly every week during the holidays that’s going to drive demand. And these make for great gifts and great stocking stuffers.”
Strategic trading card sales — which exclude sports — are up 103% year-to-date through August, while non-strategic card sales, which tend to be collectible pop culture or sports cards, are up 48%, according to market research firm Circana.
Target’s trading card sales are up nearly 70% year-to-date, with annual revenue from the category expected to top $1 billion.
Sales on some online platforms are rising even faster. Walmart Marketplace reported a 200% jump in trading card sales from February 2024 to June 2025, with Pokémon sales up more than tenfold year-over-year during the same period, the company first told Axios. The retailer has even launched a new weekly influencer livestream series focused on sports collectibles.
Since 2021, strategic card sales have grown by $891 million, or 139%, to total $1.5 billion, according to Circana. Sales of non-strategic cards and collectible stickers climbed by $565 million, or 156%, to $925 million in the same period, Circana said.
Millennials and Gen Z customers have been crucial for growth, said Juli Lennett, vice president and industry advisor for Circana’s U.S. toys practice.
“Lots of adults are buying these because it brings them back to a time when they had no cares in the world,” Lennett said. “It’s an affordable luxury with the economy right now. Some couldn’t afford cards as kids and now they have their own money and no one’s there to say ‘no’.”
Some buyers also treat cards like alternative investments. Through August, the value of Pokémon cards has delivered a cumulative return of 3,821% since 2004, according to an index by analytics firm Card Ladder, the Wall Street Journal reported. To combat online resellers, many stores now limit purchases to two packs per customer.
While the trading card category has boomed this year, not everyone is convinced the segment will boost sales during the peak holiday shopping season. Within the past six months, 19% of adults said they purchased Pokémon cards for themselves, signaling they may not be buying them for others in the weeks ahead, according to Circana.
“There has been steady growth in the category, but a large chunk of buyers are purchasing for themselves. There isn’t as much gifting here as you see in other toys,” Lennett said.
Pokemon cards released in 1999
Yvonne Hemsey | Hulton Archive | Getty Images
A year-round rush
What trading cards may lack in holiday flair, they make up for in consistency.
Cards stand apart from most toy categories in two key ways: they are frequently self-purchased and not “super seasonal,” Lennett said.
“Cards sell just as well in March or July as they do in December,” she said. “That makes them very attractive to retailers trying to offset seasonal risk.”
Target, which often gets a bump from merchandise tied to holidays, has tried to capitalize on the year-round fervor for cards.
“We expanded our assortment. We increased the number of drops that we have. We put trading cards in a more prominent place in store, did bolder displays and the business has responded,” Gomez said. “We don’t see the business slowing and we see it continuing to grow in popularity.”
Pokémon remains the category’s top performer, with card sales topping $1 billion last year — it’s the first toy brand to hit that milestone in the U.S., according to Circana. Sports cards are also becoming more popular, particularly among teen boys, with NFL packs leading the charge.
“A lot of different people are coming in to buy. You have your adult collector who’s buying for themselves, but we also see a lot of families coming in with kids requesting them and asking their parents for trading cards,” Gomez said. “It’s a great gift for parents, for kids, especially if they know that they’re into sports or Pokémon.”
While contemporary releases are booming across people aged eight to 28, vintage cards — typically pre-1970s — haven’t connected as strongly with Gen Z and Gen Alpha collectors.
“The majority of my customers aren’t looking for vintage,” Matthew Winkelried, CEO of New York-based Bleecker Trading, told CNBC. “Younger people don’t want to dig through 1960s cards unless they see a Mickey Mantle or Hank Aaron. Plus, the scarcity and price of vintage cards make it a tough entry point.”
Topps trading cards are arranged for a photograph in Richmond, Virginia.
Jay Paul | Bloomberg | Getty Images
Changing customers
After a near-collapse in the 1990s due to overproduction, the trading card industry has rebounded. Growth has been particularly strong since the pandemic, propelled by a blend of nostalgia, community and, for some, investment potential.
For many, cards offer a sense of belonging — whether it’s exchanging cards or playing a game like Pokémon or Magic: The Gathering.
“You still have the game players, and that’s a really tight-knit community,” said Jason Howarth, senior vice president of marketing and athlete relations at Panini America, which supplies sports cards to retailers like Target and Walmart. “Among sports fans, there’s a huge sense of camaraderie around trading. And with Pokémon too, I’ve heard game nights still play a major role in keeping that ecosystem alive.”
For those looking to cards as a store of value, Pokémon cards often prove to be a stronger investment than their sports counterparts, said Winkelried of Bleecker Trading.
“Maybe a highly touted rookie joins the league, and you buy their card early hoping it’ll rise in value,” he said. “The value can change week to week. It’s volatile like a stock.”
He added: “Pokémon is like a commodity. Pikachu can’t tear an ACL or get a DUI. Supply is limited, so the market is more stable.”
Looking past the holidays, major retailers are focusing on building the category’s long-term future. Target is betting on exclusive sets, limited specialty drops and drawing a more diverse consumer base.
“We are looking at reaching not only breadth of age with trading cards, but also gender,” Gomez said.
That process is already underway. The WNBA is now one of the fastest-growing segments in sports cards, particularly among young girls.
And with the 2026 FIFA World Cup spanning the U.S., Canada, and Mexico, soccer is poised to surge next.
“Caitlin Clark, Paige Bueckers and Angel Reese have done wonders for the WNBA trading card business,” Howarth said. “Once it hits June, the U.S. marketplace is going to be taken over by soccer. Fans already know the global stars like Messi, but with the World Cup being held here, at least four or five players will skyrocket in popularity and get recognized.”